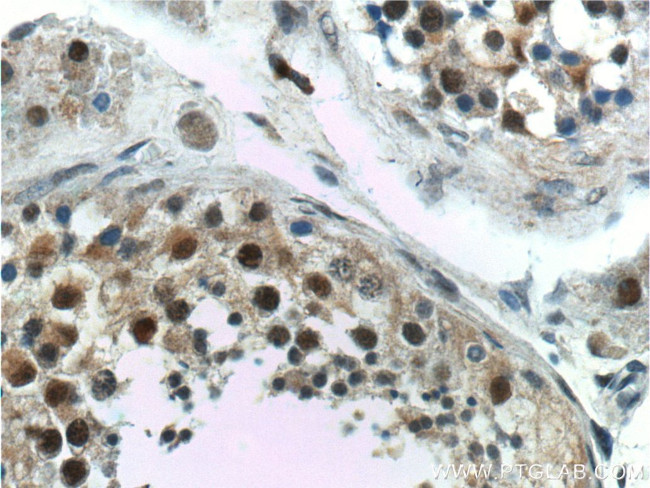
GTF2A1 Antibody in Immunohistochemistry (Paraffin) (IHC (P))

Search
Proteintech
GTF2A1 Polyclonal Antibody
{{$productOrderCtrl.translations['antibody.pdp.commerceCard.promotion.promotions']}}
{{$productOrderCtrl.translations['antibody.pdp.commerceCard.promotion.viewpromo']}}
{{$productOrderCtrl.translations['antibody.pdp.commerceCard.promotion.promocode']}}: {{promo.promoCode}} {{promo.promoTitle}} {{promo.promoDescription}}. {{$productOrderCtrl.translations['antibody.pdp.commerceCard.promotion.learnmore']}}
产品信息
21381-1-AP
种属反应
宿主/亚型
分类
类型
抗原
偶联物
形式
浓度
规格
纯化类型
保存液
内含物
保存条件
运输条件
产品详细信息
Immunogen sequence: MANSANTNT VPKLYRSVIE DVINDVRDIF LDDGVDEQVL MELKTLWENK LMQSRAVDGF HSEEQQLLLQ VQQQHQPQQQ QHHHHHHHQQ AQPQQTVPQQ AQTQQVLIPA SQQATAPQVI VPDSKLIQHM NASNMSAAAT AATLALPAGV TPVQQILTNS GQLLQVVRAA NGAQYIFQPQ QSVVLQQQVI PQMQPGGVQA PVIQQVLAPL PGGISPQTGV IIQPQQILFT GNKTQVIPTT VAAPTPAQAQ ITATGQQQPQ AQPAQTQAPL VLQVDGTGDT SSEEDEDEEE DYDDDEEEDK EKDGAEDGQV EEEPLNSEDD VSDEEGQELF D (1-330 aa encoded by BC107156)
靶标信息
Accurate transcription initiation on TATA-containing class II genes involves the ordered assembly of RNA polymerase II (POLR2A) and several general initiation factors. One of these factors is TFIIA, which when purified from HeLa extracts consists of 35-, 19-, and 12-kD subunits.
仅用于科研。不用于诊断过程。未经明确授权不得转售。
篇参考文献 (0)
生物信息学
蛋白别名: general transcription factor 2a, 1; general transcription factor IIA 1; General transcription factor IIA subunit 1; general transcription factor IIa, 1 (37kD and 19kD subunits); general transcription factor IIA, 1, 19/37kDa; glucose regulated protein, 58kD pseudogene; TFIIA alpha/beta; TFIIA alpha/beta subunits; TFIIA large subunit; TFIIA-42; TFIIAL; Transcription initiation factor IIA subunit 1; Transcription initiation factor TFIIA 42 kDa subunit
基因别名: 6330549H03Rik; AA536742; AA959775; AW060250; GTF2A1; Tf2a; TF2A1; TFIIA; TFIIA-42; Tfiia1; TfIIAa/b; TFIIAL
UniProt ID: (Human) P52655, (Mouse) Q99PM3, (Rat) O08949
Entrez Gene ID: (Human) 2957, (Mouse) 83602, (Rat) 83830